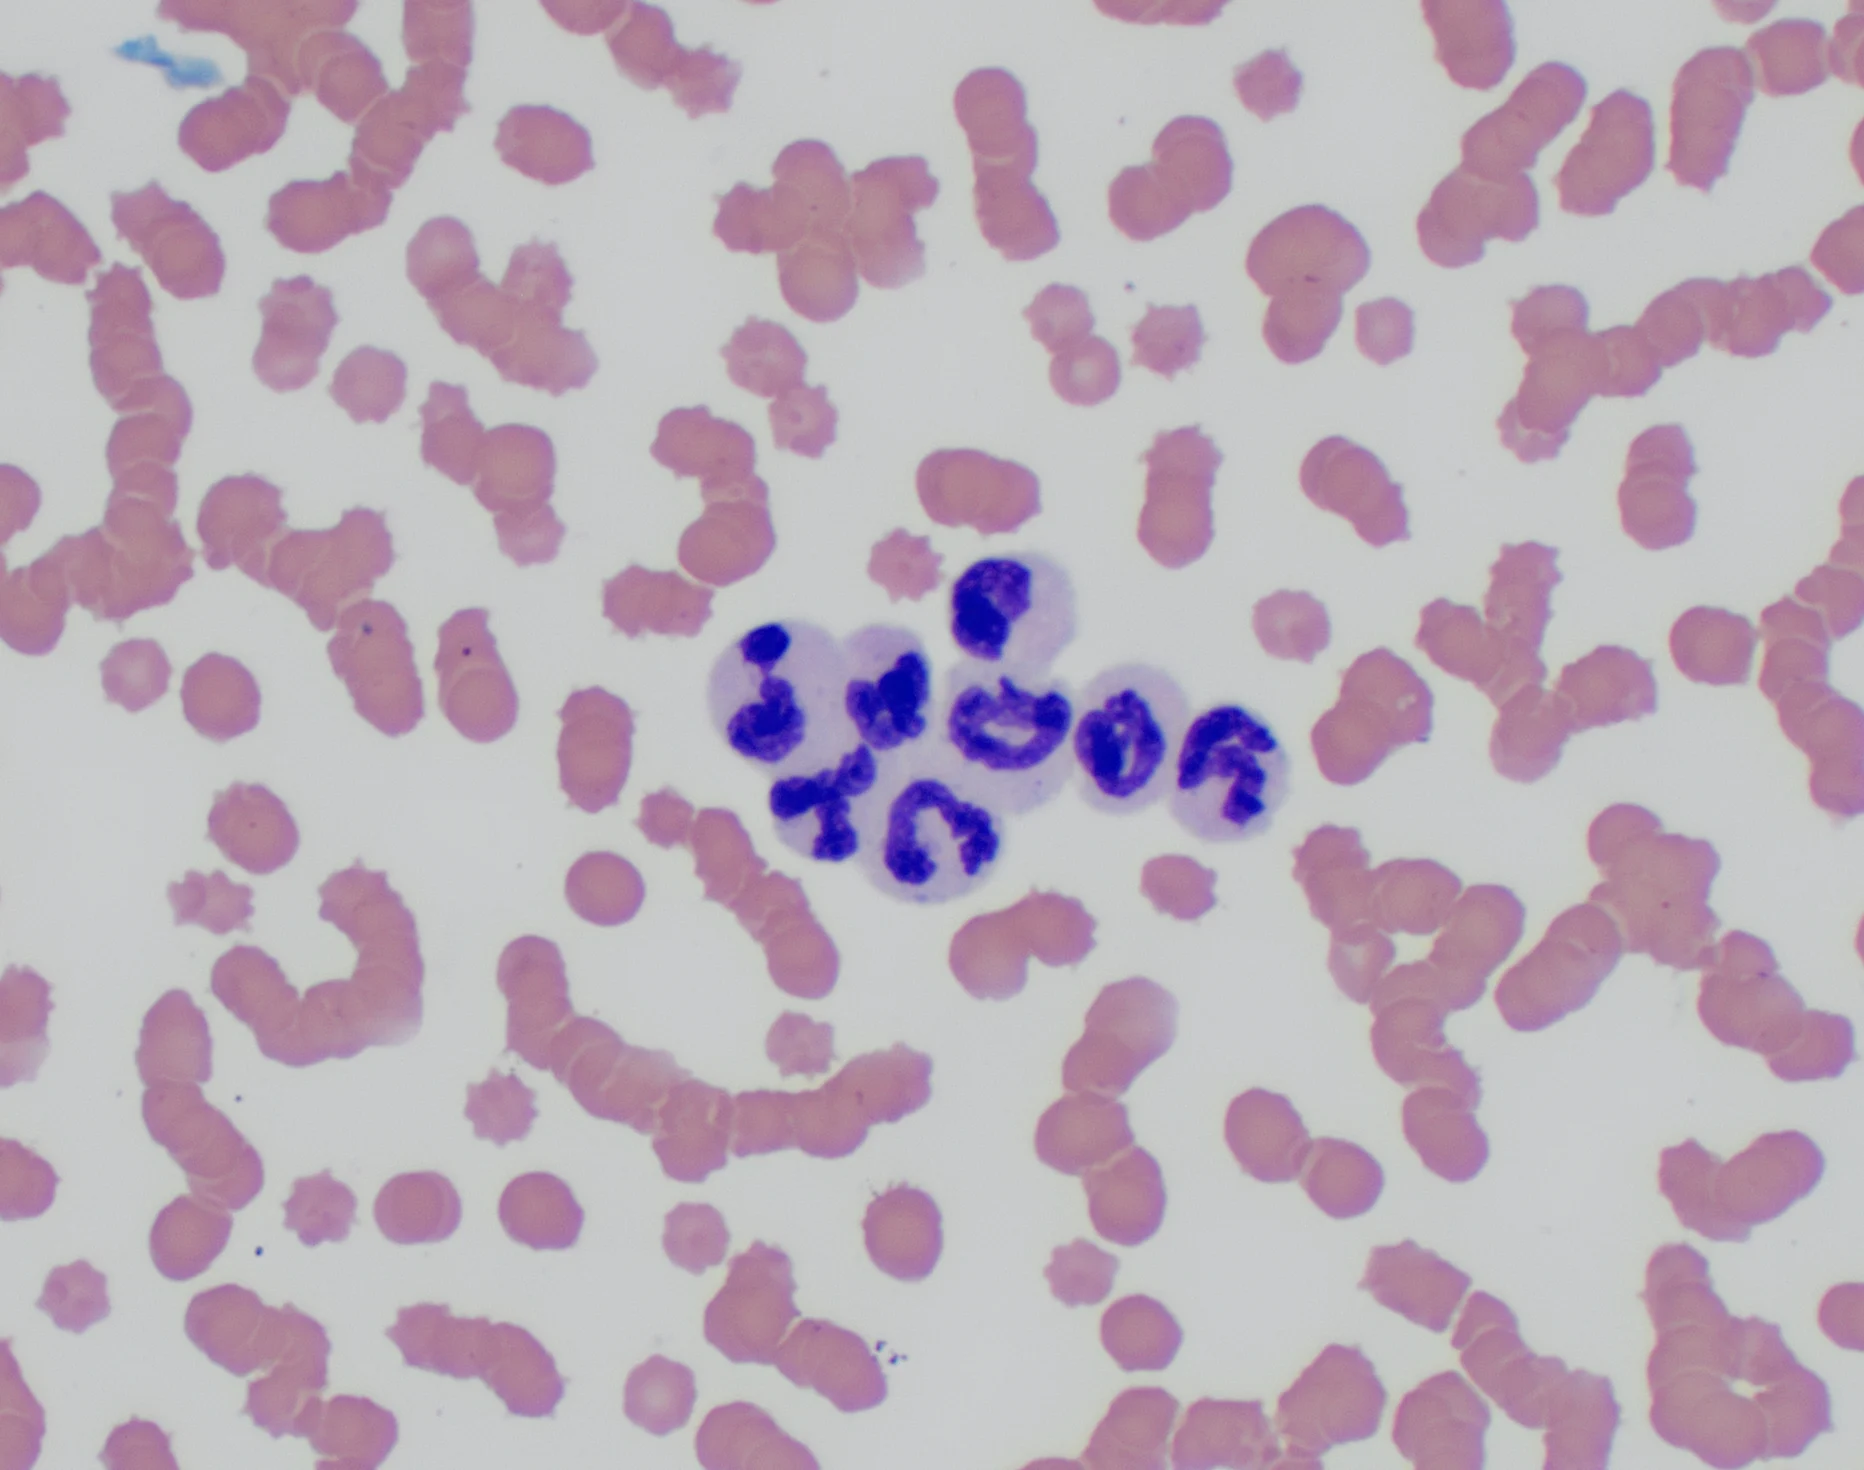

Neutropenia can be a significant hematopoietic abnormality and is typically associated with severe inflammation (increased tissue demand for neutrophils), bone marrow disease (decreased production of neutrophils), or immune-mediated disease (destruction of neutrophils; less common); however, some patients, especially cats, have neutropenia with no clinical signs or apparent cause.
Ask the Expert: Why do so many apparently healthy cats appear neutropenic on routine CBC?
Measured neutropenia in an apparently healthy cat may be due to sample error, normal variation, subclinical disease, or idiopathic disease.
Error of Sample Clotting
Clotted samples are most often associated with decreased platelet counts on CBC. The effect of clotting on leukocyte counts is less predictable; however, decreased counts can occur if leukocytes become trapped in a fibrin meshwork. Ideally, if a sample is clotted, a new sample should be collected for CBC. If this is not possible, counts obtained from the clotted sample should be interpreted with caution.
Error of Automated Differential
Hematology analyzers count thousands of WBCs and often produce precise and accurate counts and differentials with veterinary-specific software, especially in healthy patients with normal cell morphology; however, studies of reference laboratory analyzers often report higher error rates of differential counts in cats.1,2 One brand of reference laboratory analyzer could not obtain differential counts on 18% of feline specimens, compared with 3% to 15% of specimens from other species.3 In-clinic analyzers are also susceptible to errors; one hematology analyzer produced falsely low neutrophil counts in 13% of feline and 15% of canine samples.4,5 Some counts were mildly decreased compared with the reference method, but other counts were markedly decreased (up to 65% lower). Erroneous differentials with falsely low neutrophil counts are more likely in patients with inflammatory disease and a left shift, as band and other immature neutrophils are often misclassified as monocytes or lymphocytes.2,4,5
Error of Manual Differential
A manual WBC differential is prone to random and human error, particularly with insufficient staff experience or training.6 Manual differentials are more accurate than automated differentials, however, and are preferred in patients with circulating immature neutrophils, neoplastic cells, or other atypical cells that cannot be properly classified by an analyzer. Manual differentials are recommended if these cells are suspected based on clinical presentation, abnormal analyzer scattergrams, and/or analyzer flags.
Manual differentials are performed by counting 100 WBCs in the body of a blood smear, but WBCs must be evenly distributed for the result to be reasonably accurate. WBC clumping occasionally occurs in blood smears, making it difficult to obtain an accurate differential (Figure 1). Uneven distribution of WBCs can also occur, with neutrophils preferentially spreading to the edge and lymphocytes remaining in the body of the smear (Figure 2). If uneven distribution is present but not detected at low power (eg, 10× magnification), a manual differential in the body of the smear produces a falsely high percentage of lymphocytes and a falsely low percentage of neutrophils. In cases of WBC clumping or uneven distribution, creating a new blood smear may result in resolution; alternatively, counting a higher number of WBCs (eg, 200, 300) in different areas of the smear can help minimize effects of irregular distribution and produce a more accurate differential count.
Clump of leukocytes in a feline blood smear. Neutrophils typically clump with neutrophils, and lymphocytes typically clump with lymphocytes. Manual differential results can vary greatly depending on which clumps are counted.


Feathered edge (A) and body (B) of a feline blood smear. Most neutrophils are pushed to the edge of the smear and not counted when a differential is performed in the body of the smear, producing false neutropenia.
Mild or Transient Neutropenia
Most reference intervals encompass 95% of healthy patients; therefore, low numbers of healthy patients transiently or persistently have neutrophil counts at the low end of or slightly below the reference interval. Mild neutropenia (according to the reference interval) in a cat with no left shift, toxic change, or clinical signs may represent the normal neutrophil count for that patient. Comparing neutrophil and other blood counts with previous CBCs may be more informative in these patients than comparing with reference intervals.
Pathologic Neutropenia
Pathologic causes should be investigated (see Potential Causes of Pathologic Neutropenia in Cats) if neutropenia is associated with clinical illness or other cytopenias and/or is consistently greater than possible normal variation. Pathologic neutropenia can be associated with a left shift and toxic change (indicating an inflammatory process) or nonregenerative anemia and/or thrombocytopenia (indicating bone marrow disease). Immune-mediated neutropenia and idiopathic neutropenia have also been reported and typically occur in isolation, causing moderate to marked neutropenia with no inflammatory changes or other cytopenias.7,8
Potential Causes of Pathologic Neutropenia in Cats6,9
FeLV
FIV
Panleukopenia virus
Bacterial infections (eg, sepsis)
Chemotherapy
Idiosyncratic or adverse drug reactions
Myelodysplasia (eg, myelodysplastic syndrome)
Myelophthisis (eg, neoplasia, fibrosis)
Immune-mediated disease
Idiopathic disease